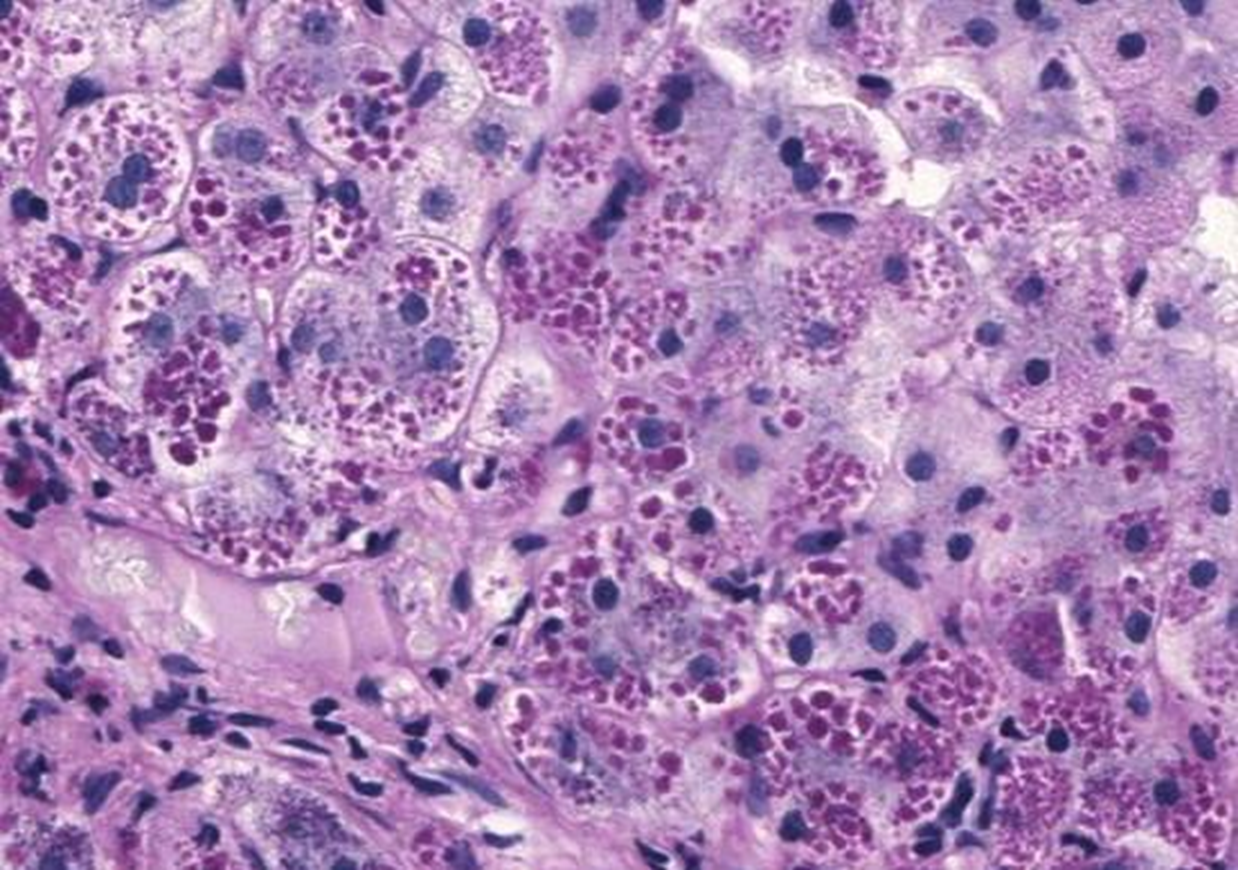
<p>PAS stain after diastase digestion</p>
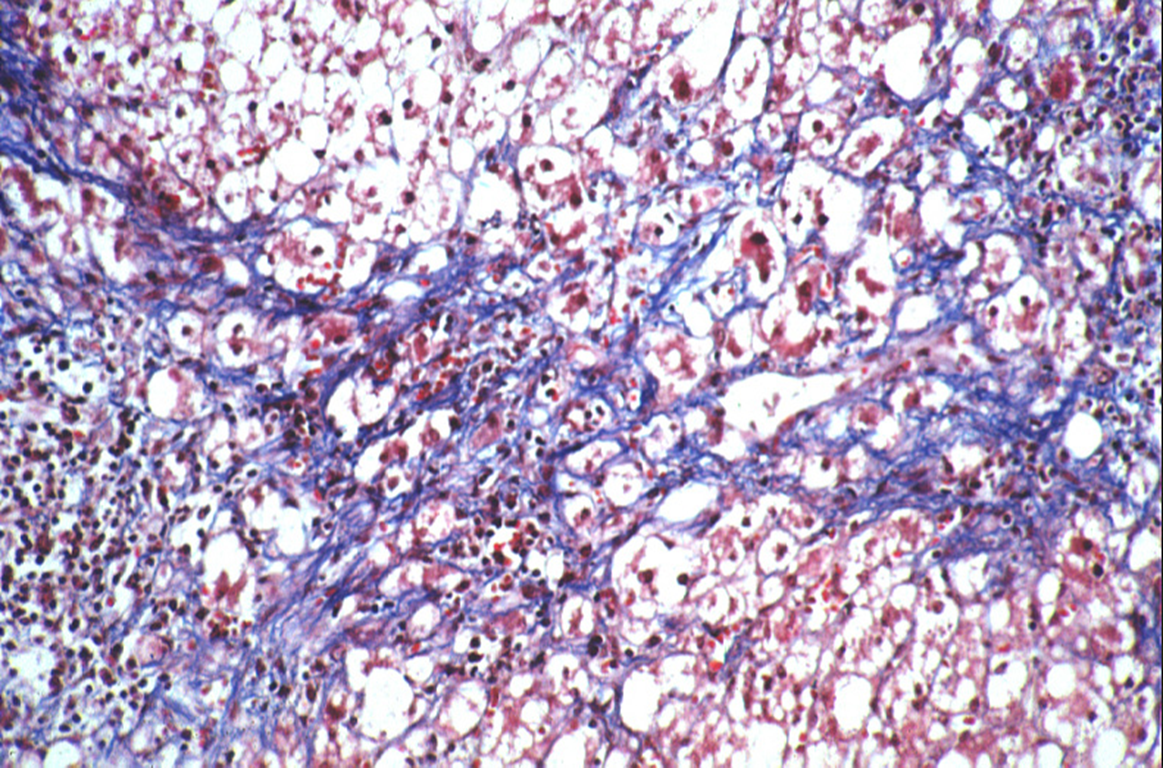
term image

1/60
Looks like no tags are added yet.
Name | Mastery | Learn | Test | Matching | Spaced | Call with Kai |
|---|
No analytics yet
Send a link to your students to track their progress
what is not one of the functions of the liver?
production of liver enzymes
T/F: liver enzyme measurements are liver function tests
F
liver function tests
albumin
bilirubin
INR
two patterns of liver enzyme elevation
hepatocellular AST/ALT
cholestatic ALP
meds, alcohol
viral hepatitis
hemochromatosis
autoimmune hep
wilsons
alpha 1 antitrypsin def
steatosis
hepatocellular
meds alcohol
obstruction
tumors
primary biliary cholangitis
primary sclerosing cholangitis
granulomatous liver disease
cholestatic
strategy for hepatocellular
serolgoic evaluation
strat for cholestatic
imaging studies
common culprits of med induced liver disease
OTC and supplements
drug induced liver injury diagnosis
exclusion
AST:ALT ratio of 2:1 or 3:1
AST and ALT NEVER >500 IU, rarely over 200 IU
alcoholic liver disease
liver assoc enzymes (LAE) >500 and <1500
viral hepatitis
med toxicity
LAE >2000
acetaminophen toxicity
ischemic injury
AST:ALT ratio in hepatocellular disease: chronic viral hep
variable, ~1
excess iron accumulation in organs
hemochromatosis
hemochromatosis diagnosis
elevated transferrin sat
C282Y homozygous (genetic testing)

elevated ALT, AST (>10X ULN)
increased gamma globulin
increased IgG
low albumin, prolonged prothrombin time
autoimmune hepatitis
autoimmune hepatitis diagnosis
ANA
SMA
liver biopsy
ANA, SMA
pANCA, SLA/LP
all ages
thyroiditis, UC, snyovitis
tx failure uncommon
type 1 AI hepatitis
antiLKM1
anti LC1
2-14 yrs
vitiligo, T1DM, thyroiditis
tx failure common
type 2 autoimmune hepatitis

low ALP + AST:ALT high (up to 4:1) in a young patient
wilsons disease
decreased ceruloplasmin, increased 24h urine copper
wilsons disease
liver + pulmonary disease (early lower lobe emphysema)
a1 antitrypsin deficiency
diagnosis for a1 antitrypsin def
dec antitrypsin level
PiZZ phenotype
PAS-D positive globules
PAS stain after diastase digestion
alpha 1 antitrypsin globules
small bowel disease, sensitive to gliadin
inflammation, epithelial damage, malabsorption
liver → innocent bystander
celiac sprue
isolated increased liver enzymes
unexplained transaminitis
celiac
elevated liver enzymes, negative diagnositc evaluation
female, obese, diabetic
hepatic steatosis
hepatic manifestation of metabolic syndrome
fatty liver:
increased abdominal girth (m >40, f >35)
elevated triglycerides (>150
low hdl (m <40, women <50)
hyperglycemia (FBS >= 100)
HTN (>130/85)
fat without inflammation, good prog rare progress
steatosis fatty liver
fat WITH inflammation, may progress to cirrhosis
steathepatitis

hepatic steatosis

steatohepatitis
steatohepatitis, pericellular fibrosis

steatohepatitis cirrhosis
may become most common cause of cirrhosis, sig cardiac morbidity and mortality
FAtty liver disease/MAFLD
approach to elevated LFTs
history (med and alcohol)
hep b and c serologies
iron studies
ceruloplasmin, urine coppers
a1antittrypsin phenotype
cholestatic injury initial eval
exclude biliary obstruction and liver mass lesions
RUQ US
common cause cholestatic injury
drug induced liver injury
stop sus meds
first step in cholestatic patterns
RUQ US
AI disorder of biliary epithelium
pruritus and hepatomegaly
asymptomatic AP elevation
primary biliary cholangitis
diagnosis for primary biliary cholangitis
antimitochondrial antibody (AMA)
Lab: marked AP elevation
biopsy: unusual
tx for PBC
ursodeoxycholic acid
immune mediated destruction of small intrahepatic bile ducts
PBC

PBC florid duct lesion
first line therapy for PBC
UDCA, improves cholestasis and lipid profile
safe and well tolerated
autoimmune disorder men and women
assoc with IBD
ASx AP elevation
RUQ pain, fever, jaundice
PSC [rimary sclerosing cholangitis
PSC diagnosis
endoscopic retrograde cholangiopancreatiography or MRCP
progressive inflammatory fibrosis and destruction of intra and extra hepatic bile ducts
80% have IBD
PSC
increased malignancy risk
cholangiocarcinoma
colon cancer
HCC
pancreatic cancer
PSC, colonscopy every year
PSC diagnosis
cholestatic liver profile
cholangiography
pANCA 65-80%
liver biopsy rarely diagnostic - 10% onion skin

PSC

PSC

alright

PBC and PSC AI disorders

clinical features compare

lab findings
most common causes of granulomatous liver disease
meds and sarcoidosis

granulomatous liver disease
approach to cholestatic liver enzyme elevation
history
abdominal US
AMA test

elevation of Alk Phos